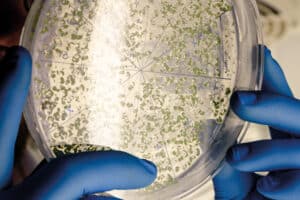

Prática da Gratidão e Pensamento Positivo
A prática da gratidão e o pensamento positivo são abordagens poderosas que podem transformar a forma como percebemos e vivemos nossas vidas. Essas práticas não apenas promovem o bem-estar emocional, mas também podem melhorar a saúde mental e física. Este texto explora os benefícios da gratidão, como cultivá-la no dia a dia e a importância do pensamento positivo. O Que é Gratidão? A gratidão é um sentimento de apreciação por aquilo que temos e pelas experiências que vivemos. É um reconhecimento das coisas boas em nossas vidas, desde os pequenos momentos até as grandes conquistas. A prática da gratidão envolve
Empresas em destaque
O Impacto da Transformação Digital no Mercado de Trabalho: Como as Empresas Estão se Adaptando
Cidade Verde
Empreendedorismo Sustentável: Como Startups Estão Moldando o Futuro da Inovação Ecológica no Brasil
Saúde e bem-estar
Saúde Mental no Trabalho: Estratégias para Manter o Bem-Estar em um Ambiente Profissional Exigente
Destaques
Educação Financeira para Jovens: Como Construir um Futuro Financeiro Seguro
Startup
Startups Brasileiras: Como Inovação e Sustentabilidade Estão Moldando o Futuro
Saúde e bem-estar
O Impacto do Bem-Estar Mental na Performance Profissional
Compromisso com você - Tudo o que acontece com à comunidade em Geral.
Leia mais...

Ricardo Nunes Eletro: O visionário que reinventou o varejo brasileiro e o mundo dos grandes negócios.
Ricardo Nunes Eletro sempre se destacou como um verdadeiro visionário. Sua trajetória é marcada por inovações que não apenas transformaram sua empresa, a Ricardo Eletro, em um ícone do setor, mas também redefiniram as expectativas do consumidor. Um início de sucesso A história de Nunes começou modestamente, vendendo frutas em sua cidade natal, Divinópolis. Esse início simples não o impediu de sonhar grande. Ele percebeu que o comércio poderia ser muito mais do que uma simples troca de produtos; poderia ser uma experiência que unisse qualidade, atendimento e inovação. Com essa visão, ele fundou a Ricardo Eletro, dando o primeiro

Alimentação Equilibrada e Saudável
Uma alimentação equilibrada e saudável é fundamental para manter a saúde física e mental, além de contribuir para a prevenção de doenças. Com a variedade de alimentos disponíveis e a crescente informação sobre nutrição, é importante entender o que significa uma alimentação equilibrada e como incorporá-la no dia a dia. Este texto explora os princípios de uma alimentação saudável, seus benefícios e dicas práticas para adotá-la. O Que é Alimentação Equilibrada? Alimentação equilibrada é aquela que fornece ao corpo todos os nutrientes necessários para funcionar de maneira adequada. Isso inclui uma variedade de alimentos que oferecem: · Carboidratos: Fonte principal

Organização e Planejamento Pessoal
A organização e o planejamento pessoal são habilidades essenciais para alcançar metas e promover um estilo de vida equilibrado. Em um mundo cheio de distrações e responsabilidades, ter um sistema eficaz de organização pode aumentar a produtividade e reduzir o estresse. Este texto explora a importância da organização e do planejamento pessoal, oferece dicas práticas e discute os benefícios dessas práticas na vida cotidiana. A Importância da Organização Pessoal A organização pessoal refere-se à capacidade de gerenciar suas tarefas, compromissos e recursos de maneira eficaz. A importância da organização inclui: · Aumento da Produtividade: Quando você está organizado, é mais

Estilo de Vida Sustentável e Consumo Consciente
Adotar um estilo de vida sustentável e praticar o consumo consciente são ações cada vez mais necessárias em um mundo que enfrenta desafios ambientais significativos. Esses conceitos envolvem a forma como vivemos, consumimos e nos relacionamos com o meio ambiente. Este texto explora a importância de um estilo de vida sustentável, os princípios do consumo consciente e dicas práticas para integrar essas práticas no dia a dia. O Que é um Estilo de Vida Sustentável? Um estilo de vida sustentável é aquele que busca minimizar o impacto ambiental das nossas ações, promovendo o uso responsável dos recursos naturais. Isso envolve

Prática da Gratidão e Pensamento Positivo
A prática da gratidão e o pensamento positivo são abordagens poderosas que podem transformar a forma como percebemos e vivemos nossas vidas. Essas práticas não apenas promovem o bem-estar emocional, mas também podem melhorar a saúde mental e física. Este texto explora os benefícios da gratidão, como cultivá-la no dia a dia e a importância do pensamento positivo. O Que é Gratidão? A gratidão é um sentimento de apreciação por aquilo que temos e pelas experiências que vivemos. É um reconhecimento das coisas boas em nossas vidas, desde os pequenos momentos até as grandes conquistas. A prática da gratidão envolve

Educação Financeira e Controle de Gastos
A educação financeira é uma habilidade essencial para a vida moderna, permitindo que indivíduos e famílias gerenciem suas finanças de forma eficaz. O controle de gastos é uma parte fundamental desse processo, ajudando a evitar dívidas e a garantir um futuro financeiro saudável. Este texto explora a importância da educação financeira, como controlar gastos e algumas dicas práticas para melhorar sua situação financeira. O Que é Educação Financeira? A educação financeira refere-se ao conhecimento e habilidades necessários para tomar decisões financeiras informadas. Isso inclui entender conceitos como: · Orçamento: Planejamento de receitas e despesas. · Investimentos: Como aplicar dinheiro de
Foi destaque

Notícias – Impulsionando o Desenvolvimento Online
Atualmente, as notícias são amplamente consideradas a maneira mais eficaz de compartilhar informação a nível global. Nos últimos anos, tem-se assistido a uma revolução no

Setor de luto cresce no Brasil
Com mais de 4 milhões de óbitos no mundo, sendo eles 525 mil no Brasil, devido ao Covid-19, houve um crescimento significativo no segmento funerário

Como manter uma vida sexual saudável na velhice
Ao falar em envelhecimento, boa parte das pessoas ignora que a sexualidade segue sendo importante nessa fase da vida. Uma vida sexual saudável é fundamental

Equilíbrio entre Trabalho e Vida Pessoal: Dicas e Estratégias para uma Vida Mais Harmoniosa
Encontrar o equilíbrio entre trabalho e vida pessoal é um desafio crescente na sociedade moderna, onde as demandas profissionais frequentemente invadem o tempo pessoal. Este

A Evolução das Notícias Através dos Tempos
O noticiário vem atravessando eras desde a primeira publicação de papel impressa na década de 1605. Daí para frente, as informações direcionadas ao público aumentaram

Endeavor Catalyst anuncia seu mais novo fundo após captar R$ 290 milhões
O Endeavor Catalyst, braço de investimento de venture capital da organização sem fins lucrativos de fomento ao empreendedorismo Endeavor, anunciou a captação de R$ 290

Startup cria plataforma para ajudar pessoas LGBTQIA+ a encontrar vagas de emprego
Após um ano de testes, a startup camaleao.co acaba de lançar a sua plataforma no mercado, cujo objetivo é conectar o público LGBTQIA+ a vagas

Inclusão social: das florestas amazônicas para as vitrines da Amazonia Vital
Os termômetros na rua marcavam 36 graus, mas a sensação térmica aliada à umidade do ar, dava a impressão de estar muito mais quente. Contudo,

Healthtech Salú recebe aporte de R$ 12 milhões
A healthtech Salú anunciou essa semana o recebimento de um aporte de R$ 12 milhões, liderado pelo SoftBank Latin America Fund. Outras empresas como a

Prática da Gratidão e Pensamento Positivo
A prática da gratidão e o pensamento positivo são abordagens poderosas que podem transformar a forma como percebemos e vivemos nossas vidas. Essas práticas não

Hidrogênio verde: 3 países lideram a produção deste combustível
A catástrofe climática em curso atualmente demanda preocupação e políticas públicas para reorganizar o sistema produtivo e desenvolver políticas públicas verdes, capazes de reduzir a
Mônica Marchett representa Impacto e Inovação em Genética e na Pecuária
Mônica Marchett representa Impacto e Inovação em Genética e na Pecuária
Cadastre-se em nossa Newsletter
Cadastre-se e receba nossas novidades. Fique por dentro de tudo o que acontece no mundo do empreendedorismo.